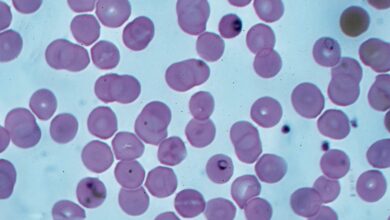

-
Focus

[Focus] Insecte stérile : une technique contre les moustiques vecteurs
Publié le 14 février 2025, par Nicolas Rousseau La technique de l’insecte stérile constitue une alternative de lutte contre la…
Lire la suite » -
Actualités

Invasion de mouches : l’enfer dans la Cité des Anges
Publié le 3 février 2025 Los Angeles est attaquée par d’infernales mouches à fruits. Ce sont essentiellement les produits frais…
Lire la suite » -
Focus

[Focus] HELP Sarl : un protocole exclusif pour dératiser les îles
Publié le 14 janvier 2025, par Nicolas Rousseau En termes de gestion des espèces invasives et nuisibles, les territoires insulaires…
Lire la suite » -
Actualités

Des chouettes pour lutter contre les rongeurs
Publié le 7 janvier 2025 La plupart des méthodes pour tuer les rats incluent les pesticides. Heureusement, le Dr Prabal…
Lire la suite » -
Focus

[Focus] L’appel d’offres, un accélérateur de croissance
Publié le 25 octobre 2024, par Nicolas Rousseau Procédure trop complexe, lourdeur administrative, démarche chronophage : nombre d’entreprises 3D, notamment les…
Lire la suite » -
Actualités

t-CRISPR : le nouvel outil d’éradication des souris par modification génétique
Publié le 16 octobre 2024 L’Université d’Adélaïde (Australie) a développé un nouvel outil de lutte antiparasitaire visant les populations invasives…
Lire la suite » -
Actualités

Des nanoparticules de virus de plantes de synthèse : la solution pour éradiquer les insectes nuisibles
Publié le 10 octobre 2024 L’Université de Californie à San Diego a récemment publié un article en septembre 2023. Dans…
Lire la suite » -
Focus

[Focus] L’inquiétante progression des fourmis invasives
Publié le 1 octobre 2024, par Nicolas Rousseau La présence des fourmis Tapinoma magnum et Wasmannia auropunctata pose problème en…
Lire la suite » -
Actualités

Le copépode cyclopoïde indigène : un prédateur de choix pour le moustique tigre
Publié le 30 septembre 2024 Le moustique tigre asiatique (Aedes albopictus) fait actuellement des parasites les plus invasifs en Europe.…
Lire la suite » -
Actualités
Découverte d’une bactérie naturelle capable d’éradiquer le paludisme : TC1
Publié le 25 septembre 2024 Les scientifiques de l’entreprise biopharmaceutique GSK ont publié un article dans la revue scientifique Science.…
Lire la suite »

